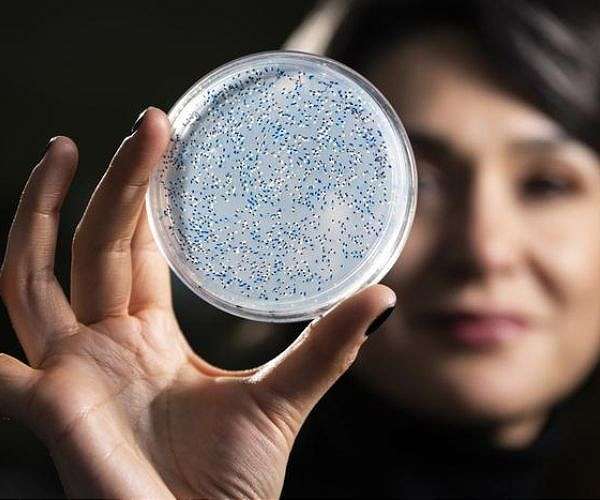

The team focused on nitrogenase, an enzyme central to the biological process that converts atmospheric nitrogen into forms that living organisms can use. Study leader Betul Kacar describes nitrogenase as an enzyme that helped set the tone for life on this planet, arguing that without it, life as we know it would not exist.
Instead of relying solely on rare and sometimes ambiguous geological samples, the researchers turned to reverse engineering, using sequence data from modern organisms to infer and rebuild ancestral forms of nitrogenase. They then inserted these ancient versions into microbes to see how they functioned under contemporary laboratory conditions, creating a direct way to probe how key metabolic processes operated billions of years ago.
Doctoral researcher Holly Rucker notes that the world of three billion years ago was dramatically different from today. Before the Great Oxidation Event, Earth's atmosphere held more carbon dioxide and methane, and life consisted mainly of anaerobic microbes. Understanding how these early organisms accessed essential nutrients such as nitrogen helps clarify how life persisted and diversified in this low oxygen environment.
Although enzymes do not fossilize, their activity can leave a record in the form of isotopic signatures preserved in rocks. For nitrogenase, these signatures involve characteristic patterns in nitrogen isotopes that geobiologists measure to infer the presence and activity of ancient life. Much previous work has assumed that ancient enzymes produced the same isotopic patterns as their modern descendants.
Rucker set out to test that assumption directly by comparing the isotopic fingerprints of reconstructed ancient nitrogenase with those generated by present day forms. The results show that the isotopic signatures preserved in the rock record match those produced by both ancient and modern nitrogenase, indicating that the key mechanism controlling this signal has remained stable over billions of years.
This stability is especially striking because the DNA sequences of nitrogenase have changed substantially over time. According to the team, the mechanism underlying the isotopic signature appears to have been conserved even as other structural and functional aspects of the enzyme evolved. Rucker now aims to understand why this core feature persisted while other properties shifted.
The project forms part of MUSE, a NASA funded astrobiology research consortium based at the University of Wisconsin-Madison and led by Kacar. MUSE brings together astrobiologists, geologists, microbiologists and molecular biologists from multiple institutions to connect evolutionary insights on Earth with the goals of current and future space missions.
With nitrogenase derived isotopes now confirmed as a robust biosignature on Earth, the findings provide a stronger framework for evaluating similar signals in extraterrestrial samples. If spacecraft or landers detect matching nitrogen isotope patterns on other planetary bodies, they could point to metabolic processes analogous to those that sustained early life here.
Kacar emphasizes that the search for life elsewhere begins with a deep understanding of our own planet's past. She argues that to interpret any potential biosignatures beyond Earth, scientists must first reconstruct how life functioned during the first billion years of Earth's history, long before complex oxygen dependent organisms reshaped the biosphere.
The new study, published in Nature Communications, demonstrates how synthetic biology can complement traditional geological approaches to ancient life. By rebuilding and testing ancestral enzymes under controlled conditions, researchers can ground their interpretations of the rock record in experimentally verified mechanisms rather than assumptions alone.
Beyond nitrogenase, the team sees this approach as a template for resurrecting other ancient enzymes tied to key planetary processes. Applying similar methods to different metabolic pathways could refine models of early Earth environments and broaden the range of biosignatures that astrobiologists can seek in data from Mars, icy moons and exoplanet atmospheres.
Research Report:Resurrected nitrogenase reveals conserved isotopic fingerprint of ancient biological nitrogen fixation
Related Links
University of Wisconsin-Madison
Explore The Early Earth at TerraDaily.com
| Subscribe Free To Our Daily Newsletters |
| Subscribe Free To Our Daily Newsletters |